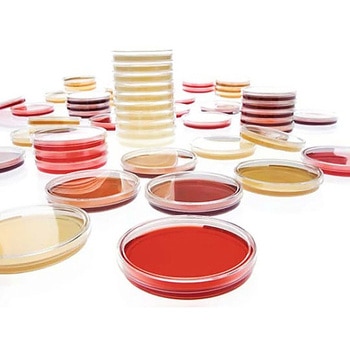
Sabouraud-Dextrose-Agar -LI acc.EP 20 146028 20PACK Merck(メルクミリポア)
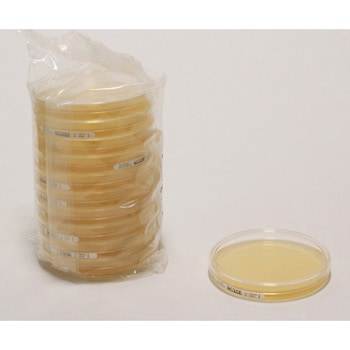
Sabouraud Dextrose Agar acc. EP+USP-LI 20mL 20 146236 20PACK Merck(メルクミリポア)

絞り込み
ブランド
- Merck(メルクミリポア)(476)
- ベクトン・ディッキンソン(369)
- 栄研化学(44)
- 島津ダイアグノスティクス(30)
- 極東製薬工業(20)
- アズワン(13)
- キッコーマンバイオケミファ(9)
- エルメックス(6)
- Solventum(ソルベンタム)(旧スリーエム ヘルスケア)(5)
- ADVANTEC(3)
- ケニス(3)
- VWR(3)
- TGK(東京硝子器械)(2)
- サン化学(2)
- PALL(ポール)(2)
- 関東化学(2)
- 林純薬工業(2)
- シグマアルドリッチ(2)
- 伊那食品工業(2)
- ブランドをもっと見る
20ページ目: 培地
「種類」から絞り込む
Sabouraud-Dextrose-Agar -LI acc.EP 20 146028 20PACKMerck(メルクミリポア)
Sabouraud-Dextrose-Agar -LI acc.EP 20 146028 20PACKMerck(メルクミリポア)¥7,819税込¥8,601
1セット(20個)
翌々日出荷
アズワン品番61-0191-01
 Tryptic Soy Agar with LTH-LI 30mL 20 146015 20PACKMerck(メルクミリポア)
Tryptic Soy Agar with LTH-LI 30mL 20 146015 20PACKMerck(メルクミリポア)¥8,319税込¥9,151
1セット(20個)
16日以内出荷
アズワン品番61-0190-97
 Columbia Blood Agar pharm. 20 146559 20PACKMerck(メルクミリポア)
Columbia Blood Agar pharm. 20 146559 20PACKMerck(メルクミリポア)¥7,798税込¥8,578
1セット(20個)
15日以内出荷
アズワン品番61-0190-74保管環境冷蔵
 Plate Count Agar acc. To ISO 4833 20 146269 20PACKMerck(メルクミリポア)
Plate Count Agar acc. To ISO 4833 20 146269 20PACKMerck(メルクミリポア)¥5,298税込¥5,828
1セット(20個)
15日以内出荷
アズワン品番61-0190-72保管環境冷蔵
 TSB with LT 90mL Q# 0804008 146484 6pcsMerck(メルクミリポア)
TSB with LT 90mL Q# 0804008 146484 6pcsMerck(メルクミリポア)¥6,698税込¥7,368
1セット(6個)
3日以内出荷
アズワン品番61-0190-66保管環境冷蔵
Sabouraud Dextrose Agar acc. EP+USP-LI 20mL 20 146236 20PACKMerck(メルクミリポア)
Sabouraud Dextrose Agar acc. EP+USP-LI 20mL 20 146236 20PACKMerck(メルクミリポア)¥7,298税込¥8,028
1セット(20個)
15日以内出荷
アズワン品番61-0190-61保管環境冷蔵
 3-way valve s/s clip 6/Pk 6×1STMerck(メルクミリポア)
3-way valve s/s clip 6/Pk 6×1STMerck(メルクミリポア)¥6,698税込¥7,368
1セット(6個)
17日以内出荷
仕様主要アプリケーション:Beer;Bottled Water;Cosmetics;Pharmaceutical Products Analysis;Bioburden Testing;Water Monitoring、概要:3方バルブ s/s クリップ品名クリップアズワン品番61-0190-50
 Rappaport Vassiliadis Medium acc.EP+USP 10mL 20 146181 20PACKMerck(メルクミリポア)
Rappaport Vassiliadis Medium acc.EP+USP 10mL 20 146181 20PACKMerck(メルクミリポア)¥6,198税込¥6,818
1セット(20個)
6日以内出荷
アズワン品番61-0190-49保管環境冷蔵
 Valve Outlet Cap+Needle 5/Pk 5×1STMerck(メルクミリポア)
Valve Outlet Cap+Needle 5/Pk 5×1STMerck(メルクミリポア)¥5,998税込¥6,598
1セット(5個)
17日以内出荷
仕様主要アプリケーション:Beer;Dairy;Bottled Water;Food and Beverage;Pharmaceutical Products Analysis;Soft Drink;Cider;Sport Drink;Wineアズワン品番61-0190-46
 EZFIT MANIFOLD CHECK VALVE, 3UNITS 3×1STMerck(メルクミリポア)
EZFIT MANIFOLD CHECK VALVE, 3UNITS 3×1STMerck(メルクミリポア)¥5,398税込¥5,938
1セット(3個)
翌々日出荷
仕様ブランド名:EZ-Fit(R)、主要アプリケーション(nm):Beer;Bottled Water;Cosmetics;Pharmaceutical Products Analysis;Bioburden Testing;Water Monitoring;Laboratory Filtration;Enviroental Analysis、概要:EZ- Fit(TM) 吸引マニホールドチェックバルブ材質ステンレススチール品名EZ-Fit 吸引マニホールドアズワン品番61-0190-44アプリケーション一般微生物分析
 55プラスモニターコネクターアダプター 5×1STMerck(メルクミリポア)
55プラスモニターコネクターアダプター 5×1STMerck(メルクミリポア)¥4,498税込¥4,948
1セット(5個)
17日以内出荷
仕様構成材質:シリコン、概要:55-Plusモニターコネクターアダプター、本アダプターは、オートクレーブ滅菌可能なNo 8ストッパー 9 mm (3/8 in.)穴(カタログ番号:XX2004718)に適しています。品名55-Plusモニターコネクターアダプター滅菌オートクレーブ滅菌可能アズワン品番61-0190-18
 LB寒天培地ナリカ
LB寒天培地ナリカ¥3,200税込¥3,520
1セット(5袋)
当日出荷
遺伝子組換え実験に最適なLB処方の栄養培地
100mL用の個包装タイプで無駄なく使えます。pH調整済み。
種類寒天培地種別100mL用保管環境室温
 モーゼルブイヨン(EE ブイヨン) 微生物学用Merck(メルクミリポア)
モーゼルブイヨン(EE ブイヨン) 微生物学用Merck(メルクミリポア)¥21,980税込¥24,178
1個
翌々日出荷
種別(MOSSELによる 腸内細菌増菌ブイヨン) 105394 500Gアズワン品番61-0194-44
 VRBD (VRBG)寒天培地 微生物学用Merck(メルクミリポア)
VRBD (VRBG)寒天培地 微生物学用Merck(メルクミリポア)¥18,980税込¥20,878
1個
8日以内出荷
種類寒天培地種別(MOSSELによる クリスタル バイオレット-ニュートラル レッド-胆汁酸塩-ブドウ糖 寒天培地) (According harm. EP/USP/JP and ISO) 110275 500Gアズワン品番61-0193-54
 Readybag(R)顆粒培地Merck(メルクミリポア)
Readybag(R)顆粒培地Merck(メルクミリポア)1箱(60包)
欠品中
Readybag(R)は秤量済みで、精製水225mLを加えるだけで調製ができます。Readybag(R)にて、1次増菌を行ったのち、選択増菌及び選択分離を行います。Readybag(R)ハーフフレーザーブイヨンを使用した検査方法は、ISO11290-1の検査法に準拠しています。
種類粉末培地
 微生物限度試験用液体培地Merck(メルクミリポア)
微生物限度試験用液体培地Merck(メルクミリポア)¥37,599税込¥41,359
1箱(100本)
16日以内出荷
微生物限度試験専用の液体培地です。キャップ形状はシリンジ挿入用にセプタムキャップになっています。品名ラベルには、製品名型番有効期限などの情報と2Dコードが貼付されています。輸送時における破損防止のため、保護材でボトル上下が固定されています。試験成績書はロット毎に発行され、メーカーHPよりダウンロードが可能です。
種類液体培地保管環境冷蔵
 SCDブイヨンMerck(メルクミリポア)
SCDブイヨンMerck(メルクミリポア)¥26,099~税込¥28,709~
1本ほか
翌々日出荷
培地充填試験に使用できます。動物由来の成分が含まれません。ご使用量に合わせて5kg包装と500g包装の2種類をラインナップしています。ロット毎にろ過性能試験データを用意しています。無菌製造工程へ安全に培地を搬入できるようにγ線滅菌済、3重包装容器になっています。
 SCDブイヨンMerck(メルクミリポア)
SCDブイヨンMerck(メルクミリポア)¥27,980~税込¥30,778~
1本ほか
翌々日出荷から43日以内出荷
培地充填試験に使用できます。ご使用量に合わせて5kg包装と500g包装の2種類をラインナップしています。ロット毎にろ過性能試験データを用意しています。無菌製造工程へ安全に培地を搬入できるようにγ線滅菌済、3重包装容器になっています。
 リステリア測定用培地Merck(メルクミリポア)
リステリア測定用培地Merck(メルクミリポア)¥11,980~税込¥13,178~
1箱
翌々日出荷から6日以内出荷
Readybag(R)で一次増菌を行った後、選択増菌及び選択分離を行います。フレーザーリステリアタイプはフレーザーリステリア増菌ブイヨン基礎培地(6-8814-71)に添加して使用します。クロモカルトリステリア選択剤はクロモカルトリステリア(ALOA寒天培地3-3605-03)に添加して使用します。
 エアーサンプラーMerck(メルクミリポア)
エアーサンプラーMerck(メルクミリポア)¥729,999税込¥802,999
1個
17日以内出荷
MAS-100 ECO TMは軽量コンパクトで持ち運びに便利です。捕集フタホコリよけカバーは、オートクレーブ滅菌が可能です。
種別MAS-100 ECOアズワン品番2-4222-01商品タイプレンタル品はこちら
 マイクロザルト・メディアアズワン
マイクロザルト・メディアアズワン¥62,400税込¥68,640
1箱(100枚)
31日以内出荷
マイクロザルト・フィルター専用の寒天培地です。培地のふたでメンブレンフィルターを釣り上げるので、ピンセットが不要です。ファネルの取り外しはワンタッチで行えます。
保管環境冷蔵
 エコノミー生培地ケニス
エコノミー生培地ケニス¥10,980税込¥12,078
1箱(100枚)
10日以内出荷
購入後、培地の調製等の必要がなく、すぐに使用することができる平板培地です。 使用しているシャーレはリブ付で重ねても滑り落ちにくい構造です。 培地表面が結露しにくい通気性パッケージを採用しています。
種類生培地保存方法要冷蔵(2~8℃)保管環境冷蔵使用期限製造日より90日
 細菌検出用培地(冷蔵)極東製薬工業
細菌検出用培地(冷蔵)極東製薬工業¥7,998税込¥8,798
1ケース(20枚×2箱)
3日以内出荷
スタンプ方式のため、操作が簡単。
各種の菌を選択的に検出。
一般細菌用は高感度に菌を検出、最短8時間で判定が可能(発色液を使用)
用途まな板・容器・手指・調理器具・機械・床・ドア・食品などにいる、目に見えない細菌を検出。培養温度・時間37℃・8~24時間保存温度(℃)2~10アズワン品番6-8778-30保管環境冷蔵
 リステリア測定用培地(冷蔵)Merck(メルクミリポア)
リステリア測定用培地(冷蔵)Merck(メルクミリポア)¥11,980~税込¥13,178~
1箱(10本)
3日以内出荷から4日以内出荷
Readybag(R)で一次増菌を行った後、選択増菌及び選択分離を行います。フレーザーリステリアタイプはフレーザー・リステリア増菌ブイヨン基礎培地(6-8814-71)に添加して使用します。クロモカルトリステリア選択剤はクロモカルトリステリア(ALOA寒天培地3-3605-03)に添加して使用します。
保管環境冷蔵保存温度(℃)-01・03/15~25℃、その他/2~8℃
 ミリフレックスプラス用寒天培地(冷蔵)Merck(メルクミリポア)
ミリフレックスプラス用寒天培地(冷蔵)Merck(メルクミリポア)¥22,980税込¥25,278
1箱(24個)
15日以内出荷
小型吸引ポンプの採用で、ろ過ステップが簡素化され試料採取が迅速に行えます。ディスプレイに表示される通りに実行するだけで、ろ過ができます。
種類寒天培地仕様(培地)10mL寒天(プラスチックカセット入)材質(フレーム)ポリエステル(30%グラスファイバー混入)、 (ディスプレイを含めたキーパッド)ポリエステル、( スリーブプロテクター)ポリエステル寸法(mm)170×270×130~135質量(kg)3.6(ヘッド部含む)規格CE規準準拠電源DC24~30V 25W保存温度(℃)2~8保管環境冷蔵
 ふき取りセット(冷蔵)ネオジェンジャパン
ふき取りセット(冷蔵)ネオジェンジャパン¥20,980税込¥23,078
1箱(50セット)
当日出荷
拭き取りしたサンプルを滅菌緩衝ペプトン水で、室温状態1~1.5時間放置して、損傷した菌を修復します。
セット内容緩衝ペプトン水(ELプレート用)2mL×50本、3Mクイックスワブ×50本保存温度(℃)8以下アズワン品番2-7437-01保管環境冷蔵



























